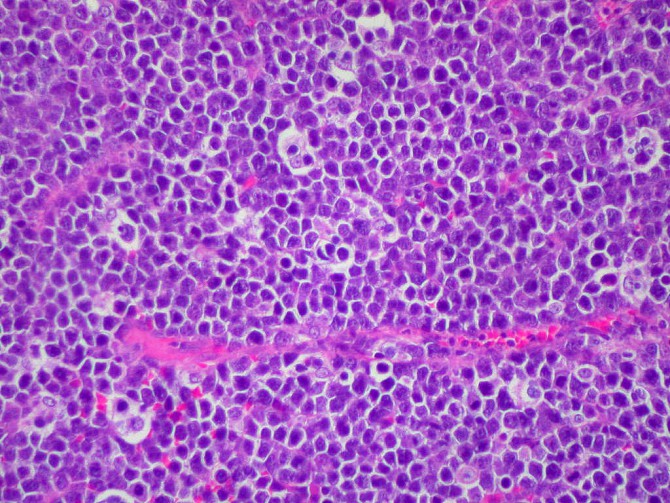

Normas de uso del foro de comentarios
Esta sección es una actividad formativa individual, no tutorizada y de periodicidad quincenal.
En ella el pediatra accede de forma independiente a los materiales didácticos.
No obstante, cada artículo lleva asociado un foro de discusión, para que los alumnos que lo deseen puedan hacer comentarios en relación a los contenidos del mismo, y recabar las opiniones, las experiencias y los conocimientos compartidos por el resto de discentes.
Se espera que estas discusiones asincrónicas y bidireccionales ayuden a establecer y construir conclusiones sobre el tema abordado.
El foro permanecerá abierto durante las fechas indicadas en la descripción de la unidad docente.
La participación del alumno en el mismo está supeditada al registro previo en la plataforma, y en caso de no ser socio de la AEP, a la formalización de la inscripción en dicha actividad.
Otras dudas que puedan surgir, en relación con la plataforma o la organización de la actividad, no deben formularse en el foro, sino a través del buzón de sugerencias de CONTÍNUUM.
No hay comentarios
No hay comentarios 












